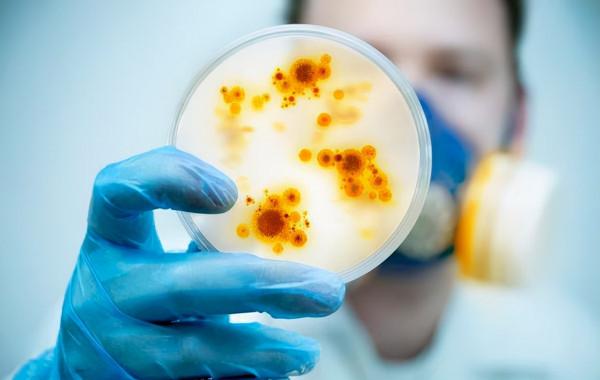
男子腎病綜合徵用激素為何會復發?如何預防復發?中醫調理方法 男子腎病綜合徵用激素為何會復發?如何預防復發?中醫調理方法

腎病綜合徵(NS)可由多種病因引起一組臨床症候群。以腎小球基膜通透性增加,臨床表現以大量蛋白尿(>3.5g/24小時)、低血漿白蛋白(<30g/L)、高脂血症和水腫為特徵,可伴有血尿、高血壓。分為原發性、繼發性和遺傳性三大類,原發性NS屬於原發性腎小球疾病,有多種病理型別構成。
繼發性腎病綜合徵的原因很多,常見者為糖尿病性腎病、腎澱粉樣變,系統性紅斑狼瘡腎炎、新生物、藥物及感染引起的腎病綜合徵。一般於小兒應著重除外遺傳性疾病、感染性疾病及過敏性紫癜等引起的繼發性腎病綜合徵,中青年則應著重除外結締組織病、感染、藥物引起的繼發性腎病綜合徵;老年則應著重考慮代謝性疾病及新生物有關的腎病綜合徵。臨床上要排除繼發於全身其他疾病引起的繼發性腎病綜合徵才能診斷為原發性腎病綜合徵。
腎病綜合徵的治療分為對症治療、免疫抑制治療和併發症治療。對症治療主要包括消腫、利尿、降低尿蛋白。方法是用免疫抑制劑和激素,包括抗凝治療,如抗血小板、聚集等,還包括限制水和鹽的攝入,適當控制蛋白質的攝入。但透過治療患者的症狀,並不能治癒疾病。有些患者使用激素類藥物治療不敏感或無效,有的甚至停藥後復發,採用中藥調理後病情控制穩定,複發率大大降低。
男子腎病綜合徵藥物治療好轉,但不久復發,中醫調理病情穩定
病例:患者xxx,男,19歲,學生。一年多前開始因出現面部、腿腳等浮腫,小便中有大量泡沫,在當地醫院被診斷為腎病綜合徵,使用激素類藥物及免疫抑制進行調脂、抗凝、利尿消腫等治療,很快臨床症狀消失,尿蛋白轉陰,患者臨床治癒出院。
出院半年,沒有出現症狀,認為病好了。又開始熬夜上網玩遊戲,吃油炸零食,幾個月後面部、下肢出現腫脹,小便中泡沫明顯增加,疲勞乏力,食慾減退,注意力不集中,嗜睡。感覺腎病復發,二次到醫院就醫,住院治療症狀好轉後出院。醫生叮囑要繼續服藥、節制飲食、規律作息。
但患者出院後並沒有遵醫囑,沒有定期檢查,病情再次發作,到一家醫院就醫,醫生採用中西醫結合療法,一方面適量用激素聯合其他藥物對症治療,一方面透過中藥方劑調理,增強臟腑功能,促進腎臟血流,增加腎臟營養,修復受損的組織,清除壞死的腎小球,使處於病態的腎小球恢復功能。後成功治癒。配合飲食調理,治療1個月後病情穩定。此後定期複查,按時用藥,沒再復發。
腎病綜合徵為什麼會復發?
腎病綜合徵復發是指原來有腎病綜合徵的患者經過正規治療以後,水腫消失,尿蛋白已經轉陰,血白蛋白升至正常,24小時尿蛋白定量低於300mg,複查時尿蛋白再次呈現陽性。對於復發的腎病綜合徵,需要積極尋找復發的原因再給予處理,比較常見的原因有感染、激素依賴。主要表現在幾個方面:
1、依從性差。多數患者沒有遵從醫生的建議逐步撤退激素,自己擅自停藥導致疾病復發,並且飲食及生活方式沒有改善,一些不良生活習慣增加復發風險。
2、感染誘發。在治療期間,患者可能會出現呼吸道感染、泌尿系統感染、面板感染等情況,均可能導致病情復發。在治療過程中或者治療一個段落,患者要避免感染,尤其在天氣冷熱交替的時候,要及時增減衣物,預防感冒。
3、激素依賴。有些患者早期使用激素治療效果較好,病情穩定後,患者在逐漸減量,甚至停藥的過程中,可能會出現病情復發。因此,減藥或停藥應在醫生指導下進行,不要自行減藥。
4、高危因素因素。由於患者在某些突發高危因素影響下,病理型別發生轉變或者疾病本身出現進展。如不當用藥、寒冷刺激、過度飲酒等。
5、基礎疾病沒控制。一些中老年患者三高沒控制或早期沒發現,隨著病情進展逐漸顯現,如果沒有進行有效控制,可能會導致病情復發加重。如高血壓、糖尿病、高尿酸等。
腎病綜合徵中醫調理方法
腎病綜合徵西醫治療,主要是口服激素類藥物,但副作用太大,容易復發。在中醫學裡,沒有腎病綜合徵這個病名,根據其臨床上的表現,主要屬於“水腫”、“虛勞”的範疇。中醫認為,腎病綜合徵主要分為脾腎陽虛型與氣陰兩虛型兩種證型。
脾腎陽虛型的腎病綜合徵患者,中藥調理以溫補脾腎陽氣為治則,方藥用附子理中丸合金匱腎氣丸加減。中藥包括:炮附子、肉桂、乾薑、高良薑、炙甘草、炒山藥、炒白朮、熟地黃、杜仲、懷牛膝、桑寄生、小茴香、生薑、大棗、黨參、茯苓等,水煎服。一般5-7劑為一個療程。服藥期間一定要注意忌口,不要吃太辣的,也儘量不要吃海鮮。
氣陰兩虛型的腎病綜合徵患者,中藥調理以補氣養陰為治則,方藥用四君子湯合益胃湯加減。中藥包括:黨參、茯苓、炒白朮、炙甘草、生黃芪、當歸、桔梗、桑白皮、地骨皮、枸杞子、大棗、雞血藤、地龍、茯苓皮、生薑皮、防己、陳皮、半夏、杜仲、牛膝、桑寄生等,水煎服。5-7劑為一個療程。服藥期間要注意忌口,儘量不要吃太辣,不要吃海鮮,防止影響療效。